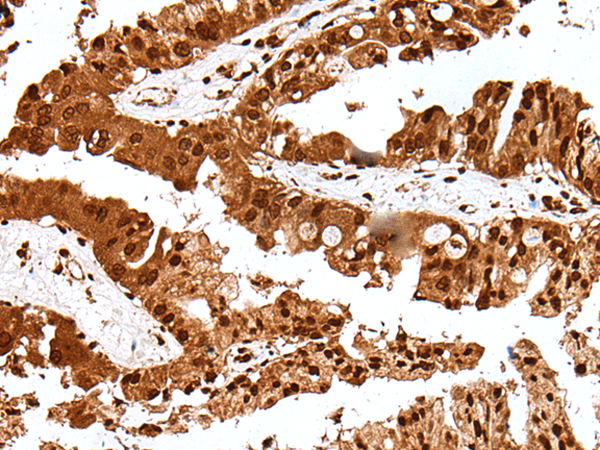
Rabbit Polyclonal Antibody to GAR1

提醒成功

搜索
Rabbit Polyclonal Antibody to GAR1
-
货号:
P09163 -
别名:
NOLA1 -
应用:
WB,IHC -
反应种属:
Human -
抗体类型:
Primary antibody -
Swissprot:
Q9NY12 -
规格:
-
数量:
-+ -
说明书:
目录价¥1980

Rabbit Polyclonal Antibody to GAR1
Description |
|---|
This gene is a member of the H/ACA snoRNPs (small nucleolar ribonucleoproteins) gene family. snoRNPs are involved in various aspects of rRNA processing and modification and have been classified into two families: C/D and H/ACA. The H/ACA snoRNPs also include the DKC1, NOLA2 and NOLA3 proteins. These four H/ACA snoRNP proteins localize to the dense fibrillar components of nucleoli and to coiled (Cajal) bodies in the nucleus. Both 18S rRNA production and rRNA pseudouridylation are impaired if any one of the four proteins is depleted. These four H/ACA snoRNP proteins are also components of the telomerase complex. The encoded protein of this gene contains two glycine- and arginine-rich domains and is related to Saccharomyces cerevisiae Gar1p. Two splice variants have been found for this gene. |
Specification |
|
|---|---|
| Aliases | NOLA1 |
| Swissprot | Q9NY12 |
| WB Predicted band size | 22 kDa |
| Host/Isotype | Rabbit IgG |
| Antibody Type | Primary antibody |
| Storage | Store at 4°C short term. Aliquot and store at -20°C long term. Avoid freeze/thaw cycles. |
| Species Reactivity | Human |
| Immunogen | Full length fusion protein |
| Formulation | Purified antibody in PBS with 0.05% sodium azide and 50% glycerol. |
Application |
|
|---|---|
| WB | 1/200-1/1000 |
| IHC | 1/25-1/100 |
| ELISA | 1/5000-1/10000 |
Product Image
- Gel: 12%SDS-PAGE, Lysate: 40 μg, Lane 1-2: Human left kidney tissue and Human fetal liver tissue lysates, Primary antibody: P09163(GAR1 Antibody) at dilution 1/250, Secondary antibody: Goat anti rabbit IgG at 1/8000 dilution, Exposure time: 2 minutes
- The image is immunohistochemistry of paraffin-embedded Human liver cancer tissue using P09163(GAR1 Antibody) at dilution 1/30. (Original magnification: ×200)
- The image is immunohistochemistry of paraffin-embedded Human breast cancer tissue using P09163(GAR1 Antibody) at dilution 1/30. (Original magnification: ×200)
For Reseach Only
Application Key:WB - Western Blot | IHC - Immunohistochemistry | ICC - Immunocytochemistry | FCM - Flow Cytometry | ELISA - Enzyme-linked Immunosorbent Assay | IP - Immunoprecipitation
#P09163

相关产品















 微信/QQ登录
微信/QQ登录


 首页
首页